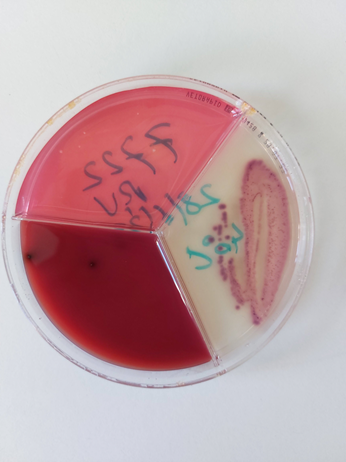

Workshop On practice culture (ILVO)
Het selectief behandelen van niet-ernstige gevallen van klinische mastitis op basis van sneltesten kan leiden tot een stevige reductie van het antibioticumgebruik zonder negatieve effecten op de prestaties van de koeien. De implementatie ervan in Vlaanderen roept echter nog heel wat praktische vragen op.
- dinsdag 4 maart 2025 van 10.30 uur tot 16 uur
Het M-team van de universiteit van Gent startte samen met ILVO, Hooibeekhoeve en DGZ in 2021 een 4 jaar durend VLAIO LA-project op.
Na het afronden van de veldproef selectief behandelen van niet-ernstige klinische mastitis delen we graag de resultaten, kennis en ervaring rond dit uitdagende thema tijdens 2 workshops. We voorzien een deel gericht op dierenartsen (voormiddag) en een deel gericht op melkveehouders en dierenartsen (namiddag). Uiteraard zijn ook andere geïnteresseerden zeer welkom op één of beide onderdelen.
Programma
10u30 |
Onthaal dierenartsen |
11u00 |
Workshop dierenartsen
|
12u00 |
Onthaal melkveehouders + lunch |
13u00 |
Workshop veehouders, erfbetreders en dierenartsen – deel 1 • Resultaten enquêtes – Lien Creytens (UGent): Benieuwd naar de kennis, interesse en de opinie van Vlaamse melkveehouders en dierenartsen rond bacteriologie van de melk, uiergezondheidsmanagement en antibioticumgebruik en -resistentie in het kader van uiergezondheid? Test jezelf en krijg inzicht in de meningen en kennisniveaus van andere Vlaamse collega’s. • Ervaringen uit de melkput – Zyncke Lipkens (MCC Vlaanderen): Een goed uiergezondheidsmanagement steunt op een correcte melktechniek en een zorgvuldige opvolging van mastitis-koeien. We delen onze praktijkervaringen uit de melkput, en analyseren veelvoorkomende aandachtspunten en risico’s die de kans op mastitis beïnvloeden. Aan de hand van observaties op melkveebedrijven krijg je concrete tips en inzichten om je melkroutine te optimaliseren en de uiergezondheid van je veestapel te verbeteren. |
14u00 |
Koffiepauze |
14u15 |
Workshop veehouders, erfbetreders en dierenartsen – deel 2 • Bespreken resultaten veldproef – Lien Creytens (UGent): Recent liep een 2-jaar durende veldproef rond selectief behandelen van niet-ernstige klinische mastitis in de Vlaamse melkveehouderij af. Wat is selectief behandelen? Wat kunnen de resultaten van deze veldproef betekenen voor de toekomst van jouw bedrijf? We delen graag onze eerste bevindingen. • Getuigenissen deelnemende veehouder en dierenarts – Hoe ga je aan de slag met selectief behandelen van mastitis en wat betekent dat concreet voor je bedrijfsvoering? Getuigenissen van deelnemende melkveehouders brengen de voordelen en aandachtspunten uit de praktijk in beeld. |
15u15 |
Netwerkmoment met drankje |
Tijdstip en locatie
Dinsdag 4 maart 2025, 10u30 – 16u00
ILVO Eenheid Dier, Scheldeweg 68, 9090 Melle
Inschrijven
De workshops zijn gratis, maar inschrijven is verplicht.

